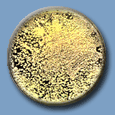

Different perineal cleaning techniques were used following bowel movements by a female test subject. Following the personal hygiene technique, the perineal area was then rinsed using a squirt bottle filled with a sterile solution containing nutrients to support the growth of bacteria (TSB). This "post hygiene" wash liquid was allowed to fall into a sterilized basin and was subsequently transferred to a sterile Erlenmeyer flask, removed to a laboratory, and evaluated for the presence of micro-organisms. The number of bacteria in the post-hygiene TSB wash signifies the efficacy of the personal hygiene step; that is, the lower the bacteria numbers in the post-hygiene wash liquid, the more effective the person hygiene technique. Read the entire study.
![]() Toilet Paper Only 0.1 ml perineal rinse liquid number of bacteria : TNTC ( estimated total bacteria 30,000,000 ) |
![]() Toilet Paper and Peri-Bottle 0.1 ml perineal rinse liquid Number of Bacteria : TNTC ( estimated total bacteria 10,000,000 ) |
![]() Bag-Type Sitz Bath Water Sample 0.1 ml perineal rinse liquid number of bacteria : TNTC ( estimated total bacteria 1,000,000 ) |
![]() Toilet Paper and Personal Hygiene Wipe 0.1 ml perineal rinse liquid Number of Bacteria : TNTC ( estimated total bacteria 24,000,000 ) |
![]() Hygenique only no Toilet Paper 0.1 ml perineal rinse liquid number of bacteria : 112 ( estimated total bacteria 112,000 ) |
![]() Hygenique Sitz bath Water Sample Number of Bacteria : 0 ( estimated total bacteria 0 ) |
-
Removes Surface Contaminants
- Glycerin cartridge and warm water cleansing therapy gently debride loosely attached revitalized tissues.
- Provides a surfactant and emollient to maintain proper pH level for skin.
- Reduces risk of infection, urinary-tract infections, potential for skin breakdown.
- Hygenique's sitz bath allows residual blood, urine, and fecal matter to flow directly into toilet through patented open / close door feature; patient soaks in clean water.
-
Reduces Perineal Pain
- Decreases pain by providing a gentle, therapeutic cleansing and soaking.
- Provides local hyperthermia to the perineal wound, relaxes the internal anal sphincter muscle.
- Prescribed for episiotomies, hemorrhoids, itching, burning, chronic diarrhea, incisions, perineal trauma and puritius ani.
-
Promotes Wound Healing
- Continuous warm water therapy concentrates heat, stimulates blood flow to perineal wound.
- Local hyperthermia increases subcutaneous perineal tissue temperature and oxygen tension to promote healing.
- Cold therapy option to reduce swelling from incision / laceration.
- Promotes healing for episiotomies, vaginectomies, fissures, fistulas, perineal abscesses, hemorrhoidectomies, anal lesions, vaginal tears.
-
Stimulates Voiding
- Continous hydrotherapy stimulates voiding, serves as alternative to catheter use, thus reduces risk of infection.
-
Reduces Potential for Nosocomial / Cross Contamination
- Individualized sitz bath / bidet system for personal use by each patient reduces risk of nosocomial infections.

OB/Postpartum/Gynecology Departments
- Episiotomy care
- Hemorrhoids
- Perineal Surgeries
- Voiding Stimulation
- Vaginectomies
- Alternative to catherer use without risk of infection
- Gynecological surgeries
- A & P resections
- A healthy alternative to douching
Med Surg
- Fistulas
- Alternative to catherer use without risk of infection
- Hemorrhoidectomies
- Perineal and rectal surgeries
- Voiding Stimulation
- Rectal abscesses and fissures
- Chronic Diarrhea
Oncology Department
- Reduce discomfort from chemotherapy and radiation treatment
- Provides hydrotherapy for perineal surgeries
- Promotes hygiene and reduces risk of infections
- Relieves discomfort from diarrhea
- Eliminates harsh rubbing from toilet tissue
- Reduces potential for skin breakdown, which can lead to infection for immune-suppressed patients
- Individual systems for patients prevent cross-contamination
Home Health and Discharge Planners
- Patients with perineal surgeries, oncology patients, geriatric patients
- Provides personal hygiene cleansing
- Reduces risk of infections
- Reduces discomfort from chemotherapy and radiation treatment
- Voiding Stimulation
- Restores dignity
- Reduces potential for urinary-tract infections